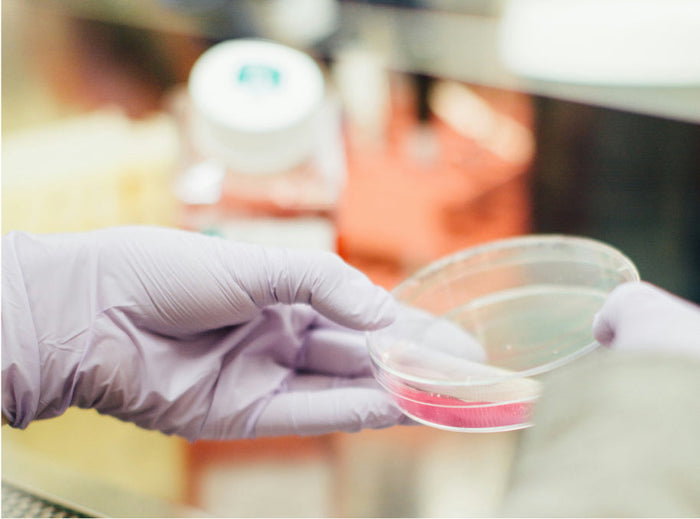

-
Our Legacy
-
Our parent company, Cultech Ltd, was established in 1994, by two microbiologists, Drs Nigel and Sue Plummer, to investigate the potential for friendly bacteria in humans. Since the company’s inception, Nigel, Sue and the team at Cultech have been researching the human microbiome and friendly bacteria and Nigel launched ProVen in 2012 to bring our own Lab4 bacteria blends to the public.

Industry experts
ProVen Biotics was created by our current CEO, Dr Nigel Plummer who is a microbiologist and world-renowned probiotics specialist.
Dr Plummer is committed to adding to the body of science and research evidence supporting the use of friendly bacteria in helping to prevent illness in humans, having first studied the positive effects of friendly bacteria on piglets being fed antibiotics in the late 1980s and early 1990s and realising their potential value for supporting human health. Dr Plummer has spoken to healthcare professionals at events all over the world over the past 30 years and is widely recognised and respected as one of the world’s pre-eminent probiotics experts.

Science-led Research
We have our own research laboratories and a large team of research scientists, who continuously work to understand more about how our bacteria blends influence the microbiome and thus other systems within the body, including digestion, immunity, athletic performance, mental health, mood, metabolism and quality of life. We invest more than £500,000 into our research every year and to date (August 2024) have undertaken more than 60 research studies, including in vitro, in vivo, and human clinical trials, and published over 100 research papers on Lab4 and/or the gut microbiome.

Our own strains
All ProVen friendly bacteria products utilise our own strains of Lactobacillus and Bifidobacteria in blends known as Lab4 and Lab4B. We have further combined our extensively researched Lab4 bacteria consortium with other bacteria and yeast strains to create two additional blends, known as Lab4P (with Lactobacillus plantarum) and Lab4S (with Saccharomyces boulardii).
ProVen Biotics For Every Life Stage
High Strength
High Strength
Our high-strength probiotics are formulated to deliver the maximum benefits for gut health, ensuring you receive the best probiotic for gut health in every easy digest capsule. With a potent blend of live cultures, our supplements provide effective support for both adults and kids.
For All Ages & Life Stages
For All Ages & Life Stages
Our gut health supplements are designed for all ages and life stages, offering tailored solutions from children’s health to women’s wellness. Whether you're looking for gut health supplements for kids, children’s vitamins, or a multivitamin for men, we have options to support everyone’s unique needs.
Bacteria Survive Stomach & Bile Acids
Bacteria Survive Stomach & Bile Acids
Our carefully selected bacterial strains, including lactobacillus acidophilus, are specifically chosen for their ability to survive harsh stomach and bile acids, ensuring maximum support for gut health. This means you can trust our products to deliver live cultures that benefit your digestive system and gut microbiome.
Guaranteed Bacteria Count to Expiry
Guaranteed Bacteria Count to Expiry
We ensure a guaranteed bacteria count to expiry, so you can be confident that our gut health supplements maintain their potency throughout their shelf life. Each easy digest capsule contains a precise amount of beneficial bacteria like lactobacillus and acidophilus, ensuring full support for gut health.
Survival at Room Temperature
Survival at Room Temperature
Our gut health supplements are formulated for stability, allowing them to survive at room temperature without compromising potency. This feature makes it easy to store and take our gut health supplements wherever life takes you.
Manufactured to cGMP Standards
Manufactured to cGMP Standards
All our products are manufactured to cGMP standards, ensuring the highest quality and safety in every batch. Our commitment to quality means you receive effective gut health supplements you can trust.
Multi-Strain
Multi-Strain
Our multi-strain gut health supplements harness the synergistic benefits of diverse bacterial strains, including lactobacillus and saccharomyces boulardii, maximising their impact on gut health. This innovative approach makes our supplements for women and kids uniquely effective for supporting the gut microbiome.
Clearly Defined Strain Numbers
Clearly Defined Strain Numbers
Each of our gut health supplements features clearly defined strain numbers, allowing you to understand exactly what you’re getting. This transparency ensures our gut health supplements meet your specific health needs with confidence.
Evidence of Safety
Evidence of Safety
We prioritise safety in our formulations, with extensive research backing the quality and safety of our gut health ingredients, like lactobacillus acidophilus and saccharomyces boulardii. This commitment ensures our products are not only effective but also safe for everyone, including our gut health supplements for kids.
Free From Artificial Colours & More
Free From Artificial Colours & More
Our gut health supplements are free from artificial colours and additives, ensuring you get a pure and natural product that supports gut health. This clean formulation makes our gut health supplements a great choice for health-conscious individuals focused on supporting their digestive enzymes and gut repair.
Gluten and Dairy Free
Gluten and Dairy Free
At ProVen, we offer gluten- and dairy-free gut health supplements, making them suitable for those with dietary restrictions or sensitivities. Our range ensures everyone in the family can benefit from high-quality gut health support without compromising dietary needs.
GMO Free
GMO Free
All of our products are GMO-free, aligning with our commitment to natural and wholesome supplements for your health. With our GMO-free gut health supplements, you can feel confident in supporting your gut health the right way.